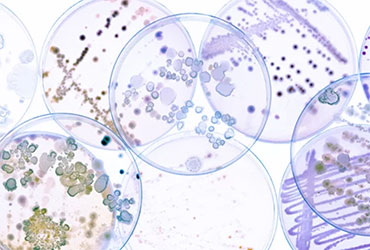

The clinical significance of polymicrobial biofilms is growing, causing a serious problem for many patients with chronic infections, including those with cystic fibrosis (CF) or chronic wounds (Antibiotics [Basel] 2022;11[12]:1731).
Polymicrobial biofilms, which affect diverse microbes through cooperation or competition, can increase the virulence and resistance of the organisms, the experts explained. “Whenever you have multiple microbes, they are probably helping and hurting each other. The net sum of those interactions affects the outcomes we see,” said George O’Toole, PhD, a professor of microbiology and immunology at Geisel School of Medicine at Dartmouth, in Hanover, N.H.
Infections in CF Patients
Dr. O’Toole and his collaborators used 16S ribosomal RNA amplicon sequencing on hundreds of sputum samples from people with CF to identify the bacteria, such as Prevotella, Pseudomonas, Streptococcus and many others. They clustered these communities based on relative abundance, generating five bacterial communities that may underlie resilient CF infections.
Computational metabolic modeling of interactions in these communities, plus measurements of clinical outcomes of patients with these clusters of microbes in their airways, identified three bacterial communities driving infections among those with CF. They are mixed and dominated by Pseudomonas and Streptococcus.
Four microbes within these genera do what Dr. O’Toole terms the “heavy metabolic lifting” undergirding CF infection and antimicrobial resistance: Prevotella, Pseudomonas, Staphylococcus and Streptococcus (mSystems 2019;4[2]:e00026-19).
Given this dynamic, the Cystic Fibrosis Foundation now advises against antimicrobial susceptibility testing on a single bacterium, Dr. O’Toole noted.
Microbiologists have known for a long time that polymicrobial interactions affect the efficacy of antimicrobials. Dr. O’Toole cited a paper that made this point (Antimicrob Agents Chemother 1976;9[5]:804-809).
It’s only as genome analysis and transcriptomics tools have become available widely in the last decade or so that it’s possible to analyze the complex communities in the airways of people with CF, Dr. O’Toole said, adding that this strategy is relevant for other chronic diseases.
“We’re well away from modeling true complexity in environmental and clinical settings, but can we take a few steps in that direction?” Dr O’Toole asked.
Biofilms and Wound Healing
Polymicrobial dynamics influence chronic wound healing more than any other variable, according to microbiologist Kendra Rumbaugh, PhD, a professor in the Department of Surgery and the director of the Burn Center of Research Excellence at Texas Tech University Health Sciences Center, in Lubbock.
Chronic wounds do not heal within an expected time, which varies by wound but is typically by 30 days after an acute wound. There may be as many as 6.5 million people with chronic wounds in the United States, Dr. Rumbaugh reported at ASM Microbe, with care for recalcitrant wounds costing an estimated $39 billion annually.
Biofilms generated by polymicrobial interactions reduce the effectiveness of standard antibiotics used for treating chronic wounds, Dr. Rumbaugh added.
“We were surprised that wound microbiome composition was the most important factor in predicting wound healing time,” Dr. Rumbaugh said, citing a retrospective study by her Texas Tech colleagues of hundreds of healed wounds. Some of the wounds healed within 90 days, whereas others did not heal until 10 years later. The researchers used DNA samples of the wound microbiome from someone’s initial visit to identify bacteria associated with slow wound healing, and built an equation that ranked the importance of bacterial load to wound healing (medRxiv 2025 Jan 25. doi:10.1111/wrr.70004).
This is the first step in a predictive model of wound healing that also accounts for the surface area of the wound, wound location and number of systemic antibiotics, among other variables, Dr. Rumbaugh said. But even at this early stage, it appears that bacterial load has a greater effect on wound healing than comorbidities like diabetes or cardiovascular disease.
“There are only so many options for treating a chronic wound now,” Dr. Rumbaugh said—typically debridement, antibiotics or amputation. Further work to understand how polymicrobial interactions build antibiotic-resistant biofilms can inform better treatments.
Dr. Rumbaugh’s lab is already working on such treatments, developing enzymes that degrade biofilms and improve the effectiveness of antimicrobials. Sometimes her surgical colleagues are more focused on the immediate need of tending to wounds, Dr. Rumbaugh noted, and the bacterial load within those wounds is not top of mind.
“The basic science will always be important,” however, Dr. Rumbaugh said, as the foundation for better chronic wound treatments.
Drs. O’Toole and Rumbaugh, who spoke at ASM Microbe 2025, in Los Angeles, reported no relevant financial disclosures.




